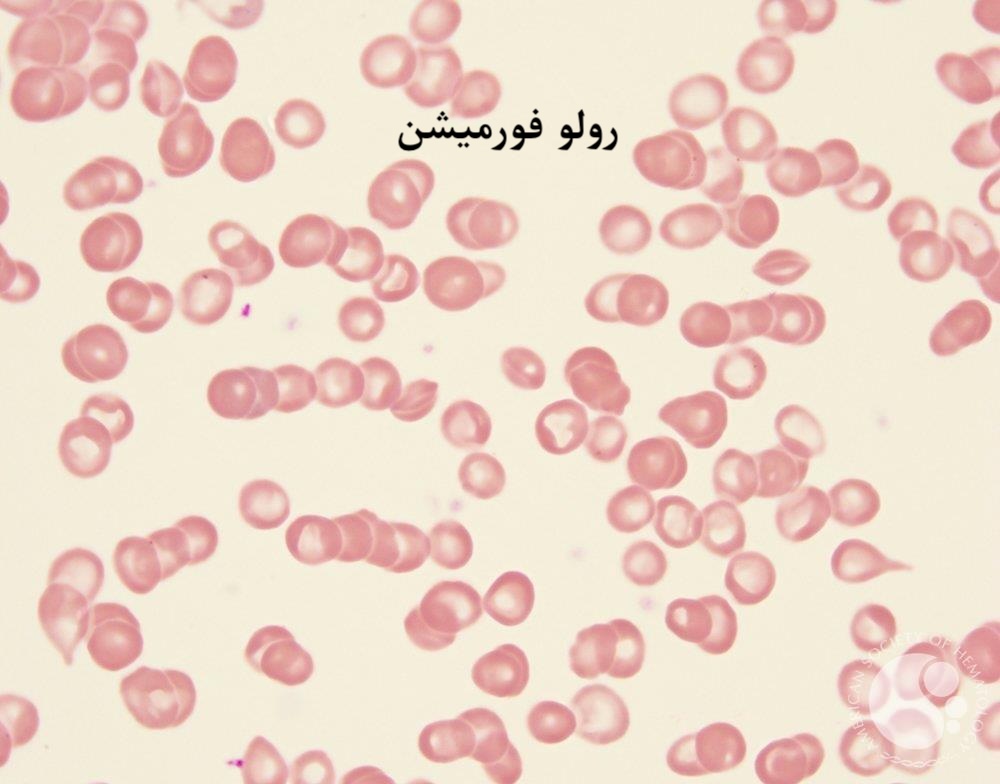
افتراق رولو از آگلوتیناسیون
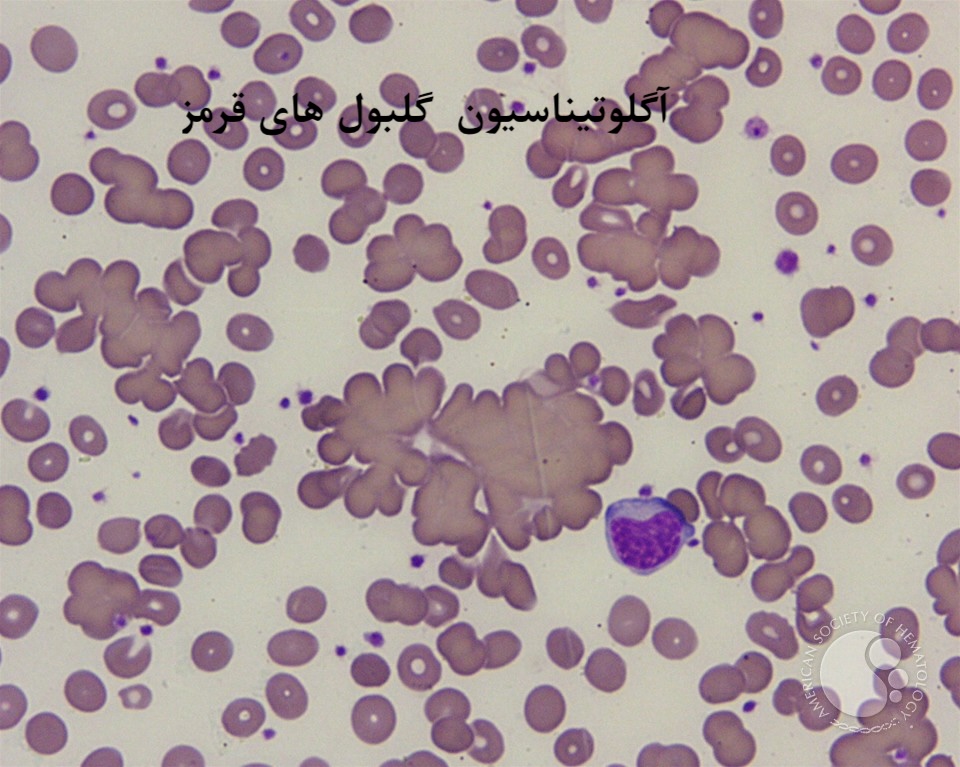
افتراق رولو از آگلوتیناسیون

جهت عضویت در کانال آموزشی در تلگرام به لینک زیر مراجعه کنید:
https://t.me/hematology_education
فهرست مطالب
تشخیص افتراقی تخصصی رولو از آگلوتیناسیون؛ بررسی مکانیسمها، تداخلات و روشهای تفکیک
مقدمه: یکی از چالشهای بنیادین در ایمونوهماتولوژی و هماتولوژی، تمایز میان تجمع فیزیولوژیک گلبولهای قرمز (Rouleaux) و واکنشهای ایمونولوژیک واقعی (True Agglutination) است. این تمایز از آن جهت حیاتی است که رولو (سودو-آگلوتیناسیون) اغلب نشانگر دیسپروتئینمی یا وضعیت التهابی بیمار است، در حالی که آگلوتیناسیون واقعی میتواند نشانه ناسازگاری خونی مرگبار یا بیماریهای همولیتیک خودایمن باشد. عدم تشخیص صحیح این دو پدیده منجر به رد صلاحیت بیمورد کیسههای خون، گزارشهای غلط CBC و سردرگمی بالینی پزشک معالج خواهد شد.
پیشنیازهای آزمایشگاهی:
🔗 دوره جامع آموزش تصویری هماتولوژی فصل پنج : آزمایش های پایهای خون و مغز استخوان
۱. فیزیوپاتولوژی تشکیل رولو (Rouleaux Formation)
رولو به آرایش خطی و منظم گلبولهای قرمز گفته میشود که در آن سلولها سطوح مقعر خود را روی یکدیگر قرار میدهند.
مکانیسم بیوفیزیکی: نقش پتانسیل زتا (Zeta Potential)
گلبولهای قرمز به دلیل وجود اسید سیالیک در غشای خود، دارای بار الکتریکی منفی هستند. این بار منفی ابری از یونهای مثبت را در اطراف سلول ایجاد میکند که به آن «پتانسیل زتا» میگویند. در حالت نرمال، این دافعه الکترواستاتیک مانع از نزدیک شدن گلبولها به فاصله کمتر از ۲۵ نانومتر میشود.
در شرایط پاتولوژیک، افزایش پروتئینهای نامتقارن پلاسما (بهویژه فیبرینوژن و گاماگلوبولینها) باعث خنثی شدن این بارهای منفی و کاهش پتانسیل زتا میشود. در نتیجه، گلبولها میتوانند به هم نزدیک شده و به دلیل کشش سطحی، آرایش رولو را تشکیل دهند.
اتیولوژی رولو:
- مالتیپل میلوما (Multiple Myeloma): شایعترین علت به دلیل افزایش شدید پاراپروتئینها.
- ماکروگلوبولینمی والدنشتروم: افزایش IgM غیراختصاصی.
- التهابات مزمن و حاد: افزایش فیبرینوژن (به عنوان پروتئین فاز حاد).
- بیماریهای کلاژن واسکولار: نظیر لوپوس (SLE).

تصویر رولو فورمیشن
۲. مکانیسم ایمونولوژیک آگلوتیناسیون (Agglutination)
آگلوتیناسیون یک فرآیند دو مرحلهای (Sensitization & Lattice formation) است که طی آن آنتیبادیها با اتصال به آنتیژنهای سطح RBC، پلهای بینسلولی ایجاد میکنند.
ویژگیهای ساختاری آگلوتیناسیون
برخلاف رولو، آگلوتیناسیون تجمعی سه بعدی، نامنظم و مستحکم است. پیوندهای آنتیژن-آنتیبادی بسیار قویتر از نیروهای کشش سطحی در رولو هستند و با تکان دادن یا شستشو به سادگی از هم گسسته نمیشوند.
مهارت تخصصی بانک خون:
🔗 آموزش کامل خواندن و درجه بندی شدت آگلوتیناسیون در بانک خون (راهنمای علمی و عملی)
انواع بالینی:
- آگلوتینینهای سرد (Cold Agglutinins): معمولاً کلاس IgM که در دمای پایین (۴ تا ۱۸ درجه) فعال میشوند.
- آگلوتینینهای گرم: کلاس IgG که معمولاً نیاز به معرف آنتیهیومن گلوبولین (AHG) دارند، اما در صورت شدت بالا میتوانند مستقیماً آگلوتیناسیون دهند.

تصویر آگلوتیناسیون
۳. تداخلات آزمایشگاهی و تفسیر اندکسها در افتراق رولو از آگلوتیناسیون
تشخیص رولو و آگلوتیناسیون تنها محدود به مشاهده میکروسکوپی نیست؛ این پدیدهها ردپای خود را در نتایج دستگاهی نیز به جا میگذارند.
الف) تداخل در شمارش کامل خون (CBC)
هر دو پدیده باعث میشوند دستگاه شمارنده سلولی (Cell Counter)، تودههای سلولی را به عنوان یک سلول واحد بزرگ شمارش کند یا کلاً در شمارش دچار خطا شود.
| پارامتر | تغییرات مورد انتظار | علت خطا |
|---|---|---|
| RBC Count | کاهش کاذب | شمارش تودهها به جای تکسلول |
| MCV | افزایش کاذب | حجم توده > حجم تک سلول |
| MCHC | افزایش کاذب (معمولاً بالای ۳۷) | فرمول محاسبه: (Hb/Hct) × 100 |
| قانون سه گانه | نقض میشود | هماتوکریت اندازهگیری شده با هموگلوبین همخوانی ندارد |
مطالعه بیشتر در مورد شمارش سلولی:
🔗 آموزش دیف هماتولوژی؛ راهنمای کامل برای کارشناسان آزمایشگاه
ب) تداخل در ایمونوهماتولوژی (بانک خون)
- تعیین گروه خونی (Reverse Typing): رولو باعث واکنش مثبت کاذب در تمام لولههای بکتایپ (A1, B, O cell) میشود.
- تست کراسمچ (Crossmatch): ایجاد ناسازگاری کاذب در فاز Immediate Spin (IS) که میتواند منجر به تاخیر در تزریق خون شود.
آموزش تکنیکهای بانک خون:
🔗 آموزش کامل سل تایپ و بک تایپ در بانک خون : راهنمای جامع برای کارشناسان
۴. پروتکلهای استاندارد تفکیک افتراق رولو از آگلوتیناسیون
برای افتراق قطعی، استفاده از متدهای زیر توصیه میشود:
روش اول: بررسی میکروسکوپی (Microscopic Examination)
- رولو: نمای “Stack of Coins”. سلولها حاشیه مشخصی دارند و با اضافه کردن یک قطره سالین در زیر لامل و فشار ملایم، از هم باز میشوند (Disperse). زمینه لام معمولاً به دلیل پروتئین بالا ته رنگ آبی/بنفش دارد.
- آگلوتیناسیون: تودههای نامنظم (Clumps). سلولها به هم جوشخورده به نظر میرسند و با اضافه کردن سالین همچنان متصل باقی میمانند.
روش دوم: تکنیک جایگزینی سالین (Saline Replacement Technique) – روش طلایی
این روش به طور اختصاصی برای حذف رولو در تستهای بانک خون (بک تایپ و کراسمچ) طراحی شده است.
مراحل اجرا:
- لولههای آزمایش (حاوی سرم بیمار و سوسپانسیون سلولی) را که واکنش مثبت نشان دادهاند، مجدداً سانتریفیوژ کنید.
- با استفاده از پیپت پاستور، سرم رویی را به طور کامل و با دقت فراوان خارج کنید (بدون برهم زدن دکمه سلولی).
- حجم معادل سرمِ برداشته شده (معمولاً ۲ قطره) نرمال سالین به لوله اضافه کنید.
- لوله را به آرامی مخلوط کرده و مجدداً سانتریفیوژ کنید (با همان دور و زمان استاندارد سرولوژی).
- دکمه سلولی را از نظر ماکروسکوپی و میکروسکوپی بررسی کنید.
تفسیر نتایج:
- واکنش منفی (پخش شدن سلولها): پدیده مشاهده شده رولو بوده است. (رقیقسازی پروتئینهای پلاسما باعث بازگشت پتانسیل زتا شد).
- واکنش مثبت (باقی ماندن کلامپها): پدیده مشاهده شده آگلوتیناسیون واقعی است. (پیوندهای آنتیبادی با سالین شکسته نمیشوند).
۵. نکته مهم: افتراق رولو از آگلوتیناسیون سرد
گاهی آگلوتیناسیون ناشی از آنتیبادیهای سرد (Cold Agglutinins) با رولو اشتباه گرفته میشود. اگر تکنیک جایگزینی سالین جواب نداد اما همچنان شک به خطای آزمایشگاهی دارید:
- نمونه را به مدت ۱۵ الی ۳۰ دقیقه در دمای ۳۷ درجه سانتیگراد انکوبه کنید.
- اگر تجمعات از بین رفتند: آگلوتیناسیون سرد (IgM) مطرح است.
- اگر تغییر نکردند و با سالین هم باز نشدند: آگلوتیناسیون گرم یا واقعی مطرح است.
جمعبندی:
مهارت در تمایز میان آرایش خطی ناشی از دیسپروتئینمی (Rouleaux) و شبکهسازی ایمونولوژیک (Agglutination)، نشانگر تسلط کارشناس بر اصول سرولوژی است. در حالی که رولو هشداری برای بررسی وضعیت پروتئینی بیمار است، آگلوتیناسیون نیازمند پیگیریهای دقیق ایمونوهماتولوژیک برای یافتن آنتیبادیهای دخیل میباشد. استفاده روتین از “تکنیک جایگزینی سالین” در موارد مشکوک، دقیقترین راهکار برای جلوگیری از خطاهای فاحش آزمایشگاهی است.
سوالات رایج در مورد افتراق رولو از آگلوتیناسیون
۱. تفاوت ظاهری اصلی بین رولو و آگلوتیناسیون زیر میکروسکوپ چیست؟
رولو به شکل منظم و شبیه ستون سکههای چیده شده روی هم (Stack of coins) دیده میشود، اما آگلوتیناسیون تودههای نامنظم و شبیه خوشه انگور است.
۲. مهمترین علت فیزیولوژیک ایجاد رولو در خون چیست؟
افزایش پروتئینهای پلاسما، به ویژه فیبرینوژن و گاماگلوبولینها که باعث کاهش پتانسیل زتا میشوند.
۳. تست طلایی برای افتراق این دو حالت کدام است؟
تست جایگزینی سالین (Saline Replacement Technique) بهترین روش برای افتراق است.
۴. نتیجه تست جایگزینی سالین در رولو چگونه است؟
در صورت وجود رولو، پس از جایگزینی سرم با سالین، تجمعات گلبولی از هم باز شده و پخش میشوند (واکنش منفی میشود).
۵. رولو چه تاثیری بر اندکسهای CBC میگذارد؟
باعث کاهش کاذب تعداد RBC و افزایش کاذب MCV و MCHC میشود.
۶. پتانسیل زتا (Zeta Potential) چیست و چه نقشی دارد؟
پتانسیل زتا بار منفی دافعهای اطراف گلبولهای قرمز است که مانع چسبیدن آنها به هم میشود. در رولو این پتانسیل کاهش مییابد.
۷. در چه بیماریهایی احتمال مشاهده رولو بیشتر است؟
در مولتیپل میلوما، ماکروگلوبولینمی والدنشتروم و بیماریهای التهابی مزمن.
۸. تفاوت آگلوتیناسیون سرد با رولو چیست؟
آگلوتیناسیون سرد ناشی از آنتیبادی IgM است و با گرم کردن نمونه در ۳۷ درجه باز میشود، اما رولو با گرم کردن لزوماً از بین نمیرود (با سالین رفع میشود).
۹. چرا رولو در تعیین گروه خونی (Reverse Typing) ایجاد خطا میکند؟
چون باعث چسبیدن گلبولهای معرف (A1, B cells) به هم میشود و نتیجه را به صورت کاذب مثبت نشان میدهد.
۱۰. آیا میتوان با شستشوی گلبولها رولو را از بین برد؟
بله، در تستهایی که نیاز به سرم بیمار نیست (مثل سل تایپ)، شستشوی گلبولها با سالین پروتئینها را حذف کرده و رولو را برطرف میکند.